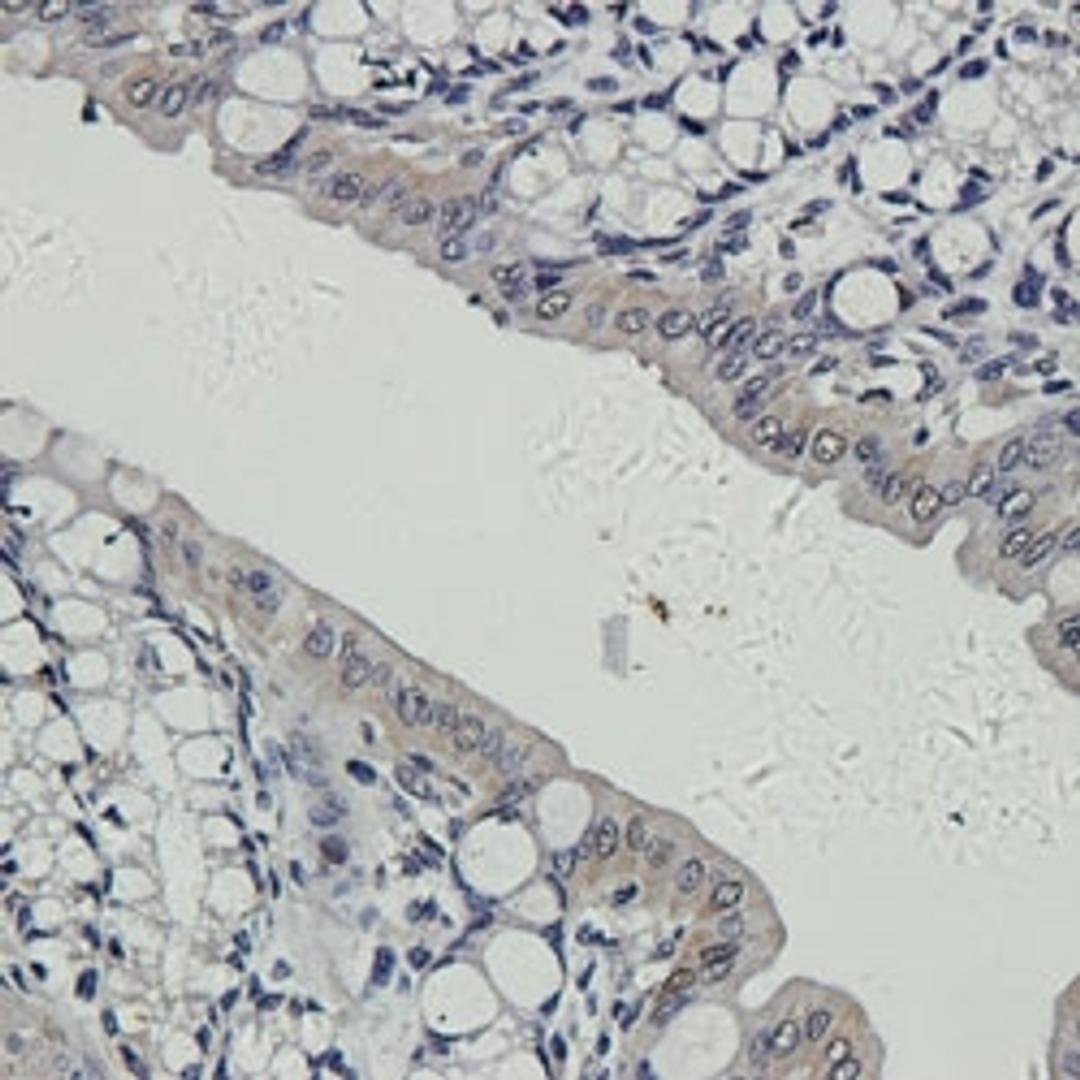

CD163 antibody
Rabbit polyclonal antibody to CD163. This protein (also known as M130); belongs to a macrophage-associated antigen; which is a member of the scavenger receptor cysteine-rich (SRCR) superfamily. CD163 acts as a receptor that scavenges hemoglobin by mediating endocytosis of haptoglobin-hemoglobin complexes.

The supplier does not provide quotations for this product through SelectScience. You can search for similar products in our Product Directory.
Rabbit polyclonal antibody to CD163. This protein (also known as M130); belongs to a macrophage-associated antigen; which is a member of the scavenger receptor cysteine-rich (SRCR) superfamily. CD163 acts as a receptor that scavenges hemoglobin by mediating endocytosis of haptoglobin-hemoglobin complexes.
- Clonality Polyclonal
- Host Rabbit
- Reactivity Human, Mouse, Rat
- Conjugate Unconjugated
- Istotype IgG
- Gene 9332
- Quantity 100µg
- Format NULL
- Storage Store at 4°C for up to two weeks. For long term storage; aliquot and store at -20°C; avoid freeze/thaw cycles.
- Buffer 10 mM PBS; 0.02% sodium azide
Applications: Immunohistochemistry (Paraffin-Embedded Sections) (IHC (P)), Western Blotting (WB)
Brochures
Advantages of using chicken immunoglobulin Y (IgY) in your research
In this product brochure, discover the similarities and differences between IgY and IgG antibodies and explore some of the advantages of using IgY antibodies in your research such as its higher avidity, lower false positive staining, and lower cross-reactivity.
Monoclonal or polyclonal antibodies: The best choice for your research
B cells secrete primary antibodies as part of the adaptive humoral immune system. This application note by Biorbyt will highlight the differences between monoclonal and polyclonal antibodies, and guide your choice for your own research.
Cancer Pathways – Apoptosis Signaling
This poster provides an overview of apoptosis, the process of programmed cell death characterized by distinct morphological characteristics and energy-dependent biochemical mechanisms.
Cancer Pathway Compendium: Downloadable Content for Your Lab
Receive your 4 free cancer pathway posters for MAPK, NF-ƘB, WNT and JAK/STAT, to help you select the best antibodies and small molecules for your cancer research assays